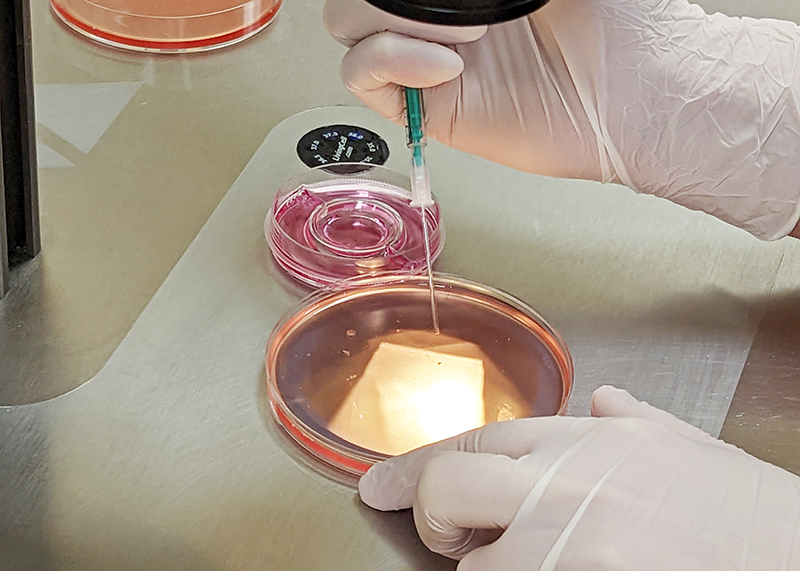
Laborarbeit

Goldschmidtstrasse 30
04103 Leipzig
info@ivf-leipzig.de
Tel.: 0341-141200
Fax: 0341-1412081
Montag – Donnerstag
7.30 – 13.00 Uhr
15.00 – 18.00 Uhr
Freitag
7.30 – 13.00 Uhr
Samstag
nur nach Absprache

Telefonische Auskünfte über Blutwerte oder andere Behandlungsergebnisse geben wir Ihnen in Leipzig gerne zwischen
13.00 und 14.00 Uhr
Telefon 03 41-14 12 00
Um den Sprechstundenablauf nicht zu stören, sind Telefongespräche mit einem Arzt in Leipzig nur nach vorheriger Absprache möglich.